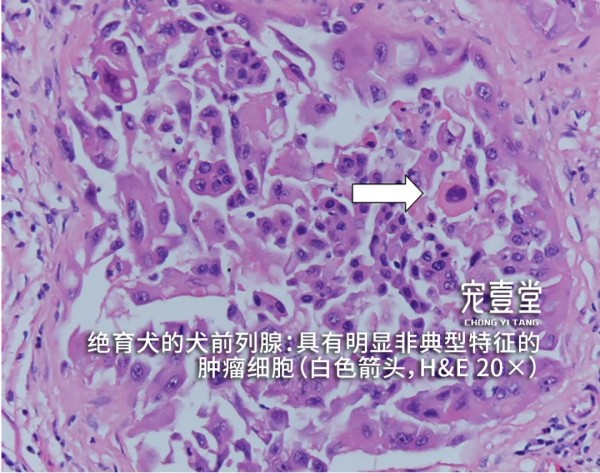

来源:宠壹堂执兽考试
前列腺肿瘤
01【发病原因】 前列腺肿瘤是去势公犬中最常见的前列腺疾病,但该病在犬中仍占少数。一般认为引发该病的原因不是睾丸分泌的激素而是肾上腺、垂体激素,最常见的前列腺肿瘤为腺癌。 前列腺癌是一种局部扩散性肿瘤,早期易转移到局部淋巴结、脾脏和骨骼,常以直接扩散的方式转移到骨、膀胱、结肠以及这些器官的周边组织,其他的转移位置包括肝、脾、肾、心脏和肾上腺。
02【疾病特征】 里急后重、大便困难、痛性尿淋漓以及步态异常。
03【临床症状】 前列腺触诊疼痛,前列腺呈不对称性肿大,但通常不是很大,形状可能不规则,质地较正常稍硬。体重减轻,下肢跛行无力;里急后重、大便困难;尿潴留或失禁、痛性尿淋漓、小便困难、多尿或少尿、口渴、血尿、下肢水肿和腹部、骨盆或腰部疼痛。
04【诊断标准】 1.根据临床症状、病史和体格检查做出初步诊断。触诊后腹部有明显疼痛反应,可摸到腹部肿块。 2.X线片可清晰看的见腹部前列腺位置的肿块。 3.超声检查可见前列腺明显增大并有强回声。当犬出现泌尿系统疾病时,除需检查肾脏、膀胱、前列腺外,睾丸及附睾也非常重要。前列腺的肿瘤有可能波及到或来自于睾丸及附睾的病变。 4.细针穿刺或活组织检查,可见肿瘤细胞。

05 【治疗和预后】 1.前列腺肿瘤未出现转移可使用前列腺全切除,但前列腺手术可能出现严重并发症,损伤尿道,使动物失禁。 2.前列腺癌的预后差。手术、化疗、激素和放疗的效果均不明显。侵袭性强,可转移至髂下淋巴结、骨盆和腰椎。死亡率高,存活率低。有报道指出平均存活时间为21天,10天内死亡率高达76%。